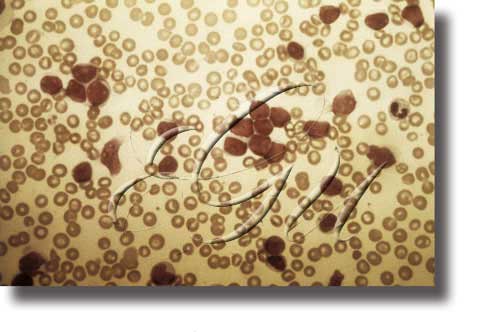

hematoloxía
hematoloxía
(
s
f
[MED]
Parte da medicina dedicada ao estudo dos elementos do sangue e ao estudo clínico e ao tratamento das enfermidades producidas polas alteracións destes elementos. Ás técnicas hematolóxicas habituais (contas globulares ou estudios de frotis sanguíneos e medulares), uníronselle os avances da bioloxía, da química e da electrónica, que permitiron novos estudios de antíxenos e de anticorpos, de cultivos de tecidos, etc, á vez que se fixeron numerosos estudios sobre a coagulación sanguínea. Estes avances repercuten no estudo clínico dos trastornos comunmente chamados enfermidades do sangue. Os transplantes de medula ósea mostráronse eficaces no tratamento dalgunhas destas enfermidades e de certas aplasias medulares.